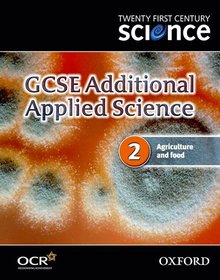
Twenty First Century Science: GCSE Additional Applied Science Module 2 Textbook

Twenty First Century Science: GCSE Additional Applied Science Module 2 Textbook
- Publisher's listprice GBP 11.99
-
5 728 Ft (5 455 Ft + 5% VAT)
The price is estimated because at the time of ordering we do not know what conversion rates will apply to HUF / product currency when the book arrives. In case HUF is weaker, the price increases slightly, in case HUF is stronger, the price goes lower slightly.
- Discount 10% (cc. 573 Ft off)
- Discounted price 5 155 Ft (4 910 Ft + 5% VAT)
Subcribe now and take benefit of a favourable price.
Subscribe
5 728 Ft

Availability
Uncertain availability. Please turn to our customer service.
Why don't you give exact delivery time?
Delivery time is estimated on our previous experiences. We give estimations only, because we order from outside Hungary, and the delivery time mainly depends on how quickly the publisher supplies the book. Faster or slower deliveries both happen, but we do our best to supply as quickly as possible.
Product details:
- Edition number and title :GCSE Additional Applied Science Module 2 Textbook
- Publisher OUP Oxford
- Date of Publication 2 March 2006
- ISBN 9780199150274
- Binding Paperback
- No. of pages64 pages
- Size 276x219x4 mm
- Weight 211 g
- Language English
- Illustrations In full colour 0
Categories
Long description:
Twenty First Century Science
BLis a suite of complementary specifications offering flexible and exciting options for science at GCSE
BLis unique in having been extensively trialled over three years with more than 6,000 students in each year
BLis motivating, stimulating and relevant.
The specifications and resources are the products of close collaboration between the University of York Science Education Group, the Nuffield Curriculum Centre, OCR, and Oxford University Press.
The GCSE Additional Applied Science course contains six modules, and students choose three of these:
BLA1 Life Care
BLA2 Agriculture and food
BLA3 Scientific detection
BLA4 Harnessing chemicals
BLA5 Communications
BLA6 Materials and performance
A comprehensive set of trialled resources is available:
For each module:
A Textbook which conveys science content in a fresh, engaging way.
A Workbook which can be used for homework and provides the student with a set of summary notes to help with revision.
A Teacher and Technician Guide with schemes of work covering the whole course, including assessments, homeworks, cover lessons, and activity sheets.
Covering all six modules:
iPack CD-ROM which includes the schemes of work in interactive form, along with video clips and PowerPoint presentations. Remember the CD-ROMs are eligible for e-learning credits.
For more information, visit:
www.twentyfirstcenturyscience.org
This course provided the student with the opportunity to study the relevance of science to them and their future; it develops their scientific literacy skills and provides them with the skills to make judgements about modern science based on risk and benefit. The traditional schemes teach the facts (many irrelevant to what our students will meet in the future) and give a cursory link to society if you are lucky and if time allows!


